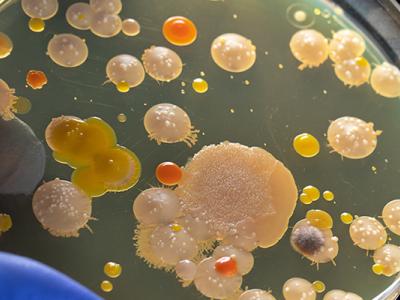

Viser hjemmesidens indhold for "Arrangementer for voksne" (335)
-
 Arrangementer for voksne
Arrangementer for voksneSamtaler om døden
Med juristen, bedemanden og stenhuggerenPosthusetUdløbet
-
Arrangementer for voksne
Tal, tilfældigheder og tipping points
Livestreamet videnskabsforedrag ved statistikprofessor Susanne DitlevsenKulturhus MåløvUdløbet
-
Arrangementer for voksne
Videnskaben bag øl
Livestreamet videnskabsforedrag ved Birgitte Skadhauge og Erik LundKulturhus MåløvUdløbet
-
 Arrangementer for voksne
Arrangementer for voksneJulequiz & julehygge
TorsdagssalonSkovlunde KulturhusUdløbet
-
 Arrangementer for voksne
Arrangementer for voksneNatur-Balance-Huset
Astrologisk kig ind i 2025Skovlunde KulturhusUdløbet
-
 Arrangementer for voksne
Arrangementer for voksne(U)nyttige Historiefacts
En cocktail af humor og historisk videnPosthusetUdløbet
-
 Arrangementer for voksne
Arrangementer for voksneMusikværksted
Jazz og rockKulturhus MåløvUdløbet
-
 Arrangementer for voksne
Arrangementer for voksneForedrag: Litteratur og meditation
Oplev meditation i både krop og sind med forfatter Niels LyngsøPosthusetUdløbet
-
 Arrangementer for voksne
Arrangementer for voksneStrikkeworkshop om TERN
Kom til en spændende og farverig workshop hvor du vil få vist forskellige måder at få tern på dit strik.Ballerup BibliotekUdløbet
-
 Arrangementer for voksne
Arrangementer for voksneStrikkeworkshop om TERN
Kom til en spændende og farverig workshop hvor du vil få vist forskellige måder at få tern på dit strik.Ballerup BibliotekUdløbet
-
 Arrangementer for voksne
Arrangementer for voksneFortidens og fremtidens vilde natur
Livestreamet videnskabsforedragKulturhus MåløvUdløbet
-
 Arrangementer for voksne
Arrangementer for voksneTALK med Digitaliseringsstyrelsen, Ballerup Kommunes digitaliseringschef og ph.d. studerende fra Rockwool fonden
Kunstig intelligens &...en jungle af beslutninger, forudsigelser og forordningerPosthusetUdløbet
-
 Arrangementer for voksne
Arrangementer for voksneKunstig intelligens & data Data DATA (TALK og udstilling)
Oplev kunstig intelligens i aktion i en 100 Kvadratmeter interaktiv datavisualiseringPosthusetUdløbet
-
 Arrangementer for voksne
Arrangementer for voksneHør mere: Hvad sker der i min vilde have i de mørke måneder?
Få mere at vide om den vilde have om efteråret og vinterenPosthusetUdløbet
-
 Arrangementer for voksne
Arrangementer for voksneGræskarskæredag
Pynt byen op til HalloweenKulturhus MåløvUdløbet
-
 Arrangementer for voksne
Arrangementer for voksneHalloween i Måløv
Er du klar til uhygge, mørke og vilde oplevelser?Kulturhus MåløvUdløbet
-
 Arrangementer for voksne
Arrangementer for voksneKunstig intelligens &...en verden med hybridkrig og desinformation
Talk med seniorforsker Flemming SplidsboelPosthusetUdløbet
-
 Arrangementer for voksne
Arrangementer for voksneAFLYST Malte Tellerup og Anders Haahr Rasmussen
En samtale om litteratur, sport og kønPosthusetUdløbet
-
 Arrangementer for voksne
Arrangementer for voksneKunstnerdag på Posthuset
Kom og oplev lokal kunst på Posthuset!PosthusetUdløbet
-
 Arrangementer for voksne
Arrangementer for voksneMellem hylderne
Ses vi til bogsnak?Ballerup BibliotekUdløbet
-
 Arrangementer for voksne
Arrangementer for voksneMusik-Banko
Så spiller musikken på Posthuset igen!!PosthusetUdløbet
-
 Arrangementer for voksne
Arrangementer for voksneHør: Historien om hvordan minkene forsvandt ud af minksagen
Foredrag med Mathilde Walter Clark, forfatteren bag bogen Det blinde ØjePosthusetUdløbet
-
 Arrangementer for voksne
Arrangementer for voksneDe østtyske spor i litteraturen
En eftermiddag om tysk litteraturPosthusetUdløbet
-
 Arrangementer for voksne
Arrangementer for voksneVær med til at skabe kultur, oplevelser og fællesskaber i Kulturhus Måløv
Den åbne ordinære generalforsamling i brugerrådetKulturhus MåløvUdløbet
-
 Arrangementer for voksne
Arrangementer for voksneMånedens kunster i Kulturhus Måløv
Anni Blangsted – Blandede bolsjerKulturhus MåløvUdløbet
-
 Arrangementer for voksne
Arrangementer for voksneMød Maria Helleberg
At skrive om SkovlundeSkovlunde KulturhusUdløbet
-
 Arrangementer for voksne
Arrangementer for voksneIdéworkshop for Naturnetværk Ballerup
Arrangeret af Vild med ViljePosthusetUdløbet
-
 Arrangementer for voksne
Arrangementer for voksneVil du læse ”Det blinde øje” og møde Mathilde Walter Clark sammen med mig?
Prøv en læseklub på én eftermiddagBallerup BibliotekUdløbet
-
 Arrangementer for voksne
Arrangementer for voksneVi fejrer FN den 24. oktober
Et symbol på håb og global enhedBallerup BibliotekUdløbet
-
 Arrangementer for voksne
Arrangementer for voksneAFLYST: Bo Tao Michaëlis: Top ti bedste krimier
Foredrag med krimieksperten, krimianmelder Bo Tao MichaëlisPosthusetUdløbet
-
 Arrangementer for voksne
Arrangementer for voksneMellem hylderne
Ses vi til bogsnak?Ballerup BibliotekUdløbet
-
 Arrangementer for voksne
Arrangementer for voksneJul i Måløv 2024
Det bliver først rigtig jul, når du har været til jul i Måløv!Kulturhus MåløvUdløbet
-
 Arrangementer for voksne
Arrangementer for voksneMellem skærmene: Workshop
Kom godt i gang med Filmstriben, eReolen og alle bibliotekets andre digitale tilbudBallerup BibliotekUdløbet
-
 Arrangementer for voksne
Arrangementer for voksneMellem skærmene: Workshop
Kom godt i gang med Filmstriben, eReolen og bibliotekets andre digitale tilbudBallerup BibliotekUdløbet
-
 Arrangementer for voksne
Arrangementer for voksneNy tufteklub i Posthuset
Velkommen i tufteklubben!PosthusetUdløbet
-
 Arrangementer for voksne
Arrangementer for voksneFredslyset fra Betlehem kommer til Ballerup
Tænd lys for en fredelig fremtid i en broget verdenBallerup BibliotekUdløbet
-
 Arrangementer for voksne
Arrangementer for voksneNytårskur med bobler og bøger
Start dit år på hyggeligste visBallerup BibliotekUdløbet
-
 Arrangementer for voksne
Arrangementer for voksneTech-Tekets juletamtam
Du er inviteret til juleafslutning!Ballerup BibliotekUdløbet
-
 Arrangementer for voksne
Arrangementer for voksneSlægtsforskningscafé
Skovlunde KulturhusSkovlunde KulturhusUdløbet
-
 Arrangementer for voksne
Arrangementer for voksneSlægtsforskningscafé 2025
Ballerup BibliotekBallerup BibliotekUdløbet
-
 Arrangementer for voksne
Arrangementer for voksneHele vejen rundt om angsten
Natur-Balance-Huset i SkovlundeSkovlunde KulturhusUdløbet
-
 Arrangementer for voksne
Arrangementer for voksneFællessang i Måløv
FyraftenssangKulturhus MåløvUdløbet
-
 Arrangementer for voksne
Arrangementer for voksneForedrag med Anders Kofoed og Maise Njor: Den nødvendige far... og mor
Hvorfor er der brug for fædre?PosthusetUdløbet
-
 Arrangementer for voksne
Arrangementer for voksneGakkede konspirationsteorier
TorsdagssalonSkovlunde KulturhusUdløbet
-
 Arrangementer for voksne
Arrangementer for voksneKinesisk nytår
Vi fejrer nytåret med dumplings!PosthusetUdløbet
-
 Arrangementer for voksne
Arrangementer for voksneLær at bruge laserskæreren i Tech-teket
IntrokursusBallerup BibliotekUdløbet
-
 Arrangementer for voksne
Arrangementer for voksneHvordan har dit indre barn det?
Natur-Balance-HusetSkovlunde KulturhusUdløbet
-
 Arrangementer for voksne
Arrangementer for voksneDNA’en omkring os
Livestreamet videnskabsforedragKulturhus MåløvUdløbet
-
 Arrangementer for voksne
Arrangementer for voksneHistorien om Skovlunde Kirke
TorsdagssalonSkovlunde KulturhusUdløbet
-
 Arrangementer for voksne
Arrangementer for voksneBarselscafé
SøvnSkovlunde KulturhusUdløbet
-
 Arrangementer for voksne
Arrangementer for voksneUdforskningen af Grønland – før og nu
Livestreamet videnskabsforedragKulturhus MåløvUdløbet
-
 Arrangementer for voksne
Arrangementer for voksneFra bøvl til balance
Natur-Balance-HusetSkovlunde KulturhusUdløbet
-
 Arrangementer for voksne
Arrangementer for voksneOplev en Klarsynsaften
Natur-Balance-HusetSkovlunde KulturhusUdløbet
-
 Arrangementer for voksne
Arrangementer for voksneHappy for No Reason
Natur-Balance-HusetSkovlunde KulturhusUdløbet
-
 Arrangementer for voksne
Arrangementer for voksneDen meningsfulde hjerne
Livestreamet videnskabsforedragKulturhus MåløvUdløbet
-
 Arrangementer for voksne
Arrangementer for voksneKoncertforedrag om Kim Larsen
TorsdagssalonUdløbet
-
 Arrangementer for voksne
Arrangementer for voksneNy tufteklub i Posthuset
Velkommen i tuftefællesskabet!PosthusetUdløbet
-
 Arrangementer for voksne
Arrangementer for voksneForedrag: Hvad skal der blive af mændene anno 2025?
Foredrag med Svend Aage MadsenPosthusetUdløbet
-
 Arrangementer for voksne
Arrangementer for voksneMellem hylderne
Ses vi til bogsnak?Ballerup BibliotekUdløbet
-
 Arrangementer for voksne
Arrangementer for voksneTyskland i forandring
Temaaften med fokus på Forbundsdagsvalget 2025PosthusetUdløbet
-
 Arrangementer for voksne
Arrangementer for voksneGeneralforsamling i Brugerrådet
ved Kulturhus MåløvKulturhus MåløvUdløbet
-
 Arrangementer for voksne
Arrangementer for voksneKage, kaffe og krimi
Krimicafé med krimiekspert Bo Tao MichaëlisSkovlunde KulturhusUdløbet
-
 Arrangementer for voksne
Arrangementer for voksneFællessang i Måløv
Fyraftenssang den 3. onsdag i månedenKulturhus MåløvUdløbet
-
 Arrangementer for voksne
Arrangementer for voksneKvindernes Kampdag med tapas, rødvin og forfatter Sara Rahmeh
Festligt helaftensarrangementKulturhus MåløvUdløbet
-
 Arrangementer for voksne
Arrangementer for voksneFilmklub
Er du vild med film og fællesskab?Ballerup BibliotekUdløbet
-
 Arrangementer for voksne
Arrangementer for voksnePå tur i Mælkevejen igennem rum og tid
Livestreamet videnskabsforedragKulturhus MåløvUdløbet
-
 Arrangementer for voksne
Arrangementer for voksneBabymassage
Barselscafé i Skovlunde KulturhusSkovlunde KulturhusUdløbet
-
 Arrangementer for voksne
Arrangementer for voksneSpis Sammen i Skovlunde Kulturhus
Skovlunde Kulturhus og Skovlunde Kirke inviterer sammen til fællesspisningSkovlunde KulturhusUdløbet
-
 Arrangementer for voksne
Arrangementer for voksneTorsdagssalon
Forbrydelser i Ballerup
– mød krimijournalist Kasper EllesøeSkovlunde KulturhusUdløbet
-
 Arrangementer for voksne
Arrangementer for voksneDybhavet – nyt fra en ukendt verden
Livestreamet videnskabsforedragKulturhus MåløvUdløbet
-
 Arrangementer for voksne
Arrangementer for voksneDR-kendte Maria Torp om pigers og kvinders rettigheder
Billedkunstneren Maria Torp fortæller om sit kunstprojektPosthusetUdløbet
-
 Arrangementer for voksne
Arrangementer for voksneMellem to kulturer – mød forfatter Sara Rahmeh
Arrangement i Hedegaven, Hedeparken 23CUdløbet
-
 Arrangementer for voksne
Arrangementer for voksneMånedens kunstner: Michela Krag-Svendsen
Det smukke i det enkleKulturhus MåløvUdløbet
-
 Arrangementer for voksne
Arrangementer for voksneWorkshop: find dine talenter og din fede energi
Hvordan kan du arbejde med alt det, som du er bedst til?PosthusetUdløbet
-
 Arrangementer for voksne
Arrangementer for voksneForedrag om "Reconnect the dots"
Kan du finde hoved og hale på verden lige nu?PosthusetUdløbet
-
 Arrangementer for voksne
Arrangementer for voksneAFLYST! Mellem skærmene: Workshop
Kom godt i gang med lydbøger, ebøger, online film og meget mereBallerup BibliotekUdløbet
-
 Arrangementer for voksne
Arrangementer for voksneForedrag om talenter
Forfrem dig til de sjove og spændende opgaverPosthusetUdløbet
-
 Arrangementer for voksne
Arrangementer for voksneKunstnerdag i Posthuset
Kom og se, hvad lokale kunstnere laverPosthusetUdløbet
-
 Arrangementer for voksne
Arrangementer for voksneFra DDR til skateboards - Auf Deutsch
En familiehistorie om at finde sig selvKulturhus MåløvUdløbet
-
Arrangementer for voksne
Arrangementer for voksneVil resistente bakterier slå os ihjel?
Livestreamet videnskabsforedragKulturhus MåløvUdløbet
-
 Arrangementer for voksne
Arrangementer for voksneMellem hylderne
Ses vi til bogsnak?Ballerup BibliotekUdløbet
-
 Arrangementer for voksne
Arrangementer for voksneMich Vraa og fortidens skygger: Trilogien om Dansk Vestindien
Mød forfatteren bag de stærke og mørke fortællingerKulturhus MåløvUdløbet
-
 Arrangementer for voksne
Arrangementer for voksneUhlala Knitwear
Workshop for dig, der har lyst til at lære at strikke med resterBallerup BibliotekUdløbet
-
 Arrangementer for voksne
Arrangementer for voksneLOKALE STEMMER
Malene Bursøe om Metakognitiv terapiKulturhus MåløvUdløbet
-
 Arrangementer for voksne
Arrangementer for voksneHør om de 50 bøger, du SKAL nå at læse!
Vi fejrer Verdens bogdag med Liselotte WiemerBallerup BibliotekUdløbet
-
 Arrangementer for voksne
Arrangementer for voksneMånedens kunstner Helle H. Rasmussen
Helle H. Rasmussen udstiller i Kulturhus MåløvKulturhus MåløvUdløbet
-
 Arrangementer for voksne
Arrangementer for voksneAFLYST: A Beautiful Game - Hvad sport kan fortælle om samfundet
How Sports Can Help Us Understand SocietyBallerup BibliotekUdløbet
-
 Arrangementer for voksne
Arrangementer for voksneForskningens døgn
En formiddag om klimaPosthusetUdløbet
-
 Arrangementer for voksne
Arrangementer for voksneByttemarked
Uge 17Kulturhus MåløvUdløbet
-
 Arrangementer for voksne
Arrangementer for voksneØstasiatisk inspiration
Kom og bliv inspireret af Ikebana (Japansk blomsterkunst) med smagsoplevelser af østen!PosthusetUdløbet
-
 Arrangementer for voksne
Arrangementer for voksneKunstig intelligens &…en rejse helt ind i maskinrummet
Kom endnu tættere på teknologien, der former din fremtidBallerup BibliotekUdløbet
-
 Arrangementer for voksne
Arrangementer for voksneAFLYST: Caspar Eric og Nye balancer
Hvordan føles det at navigere i et samfund, der ofte ikke er skabt til alle kroppe?PosthusetUdløbet
-
 Arrangementer for voksne
Arrangementer for voksneWorkshop: Stop op! – og undgå digital svindel
Forebyggelse og Tryghed i Ballerup KommuneSkovlunde KulturhusUdløbet
-
 Arrangementer for voksne
Arrangementer for voksneForedrag: Anne Kirketerp om Craft-psykologi
Mindre stress og mere ro med håndens arbejdePosthusetUdløbet
-
 Arrangementer for voksne
Arrangementer for voksneMånedens kunstner
Jonna Ellemann LandsvigKulturhus MåløvUdløbet
-
 Arrangementer for voksne
Arrangementer for voksneKom og hør om Skovlunde Byhaver
Hvad er Skovlunde Byhaver?Skovlunde KulturhusUdløbet
-
 Arrangementer for voksne
Arrangementer for voksneForedrag: Børsen gennem 400 år - unik Danmarkshistorie
Børsen - Brande, byldepest og balladePosthusetUdløbet
-
 Arrangementer for voksne
Arrangementer for voksneMåløv Mødes 2025
Vi ses til årets byfest i Måløv!Kulturhus MåløvUdløbet
-
 Arrangementer for voksne
Arrangementer for voksneLitteraGÅtur
Ballerup før og nuBallerup BibliotekUdløbet
-
 Arrangementer for voksne
Arrangementer for voksneGrundlovsfest med fællesspisning, quiz med fede præmier og foredrag med Özlem Cekic
Grundloven - den er der grund til at fejre!PosthusetUdløbet
Viser 100 af of 335 hits
Vis flere